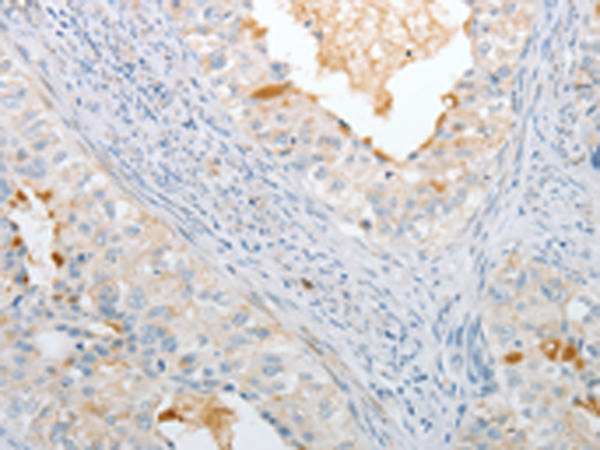

-
分类: 科研抗体货号: P07352别名: HSTF1应用: IHC反应种属: Human, Mouse
-
分类: 科研抗体货号: P07349别名: PSGD应用: WB反应种属: Human, Mouse
-
分类: 科研抗体货号: P07348别名: HO-2应用: WB反应种属: Human, Mouse, Rat
-
分类: 科研抗体货号: P07346别名: dJ1007G16.5应用: WB反应种属: Human
-
分类: 科研抗体货号: P07345别名: HD10应用: IHC反应种属: Human, Mouse, Rat
-
分类: 科研抗体货号: P07379别名: p28; IL30; IL-27; IL27A; IL-27A; IL27p28应用: IHC反应种属: Human
-
分类: 科研抗体货号: P07371别名: DORA应用: IHC反应种属: Human
-
分类: 科研抗体货号: P07377别名: IGIF; IL-18; IL-1g; IL1F4应用: WB,IHC反应种属: Human
-
分类: 科研抗体货号: P07370别名: EWI2; PGRL; CD316; EWI-2; KCT-4; CD81P3; LIR-D1应用: IHC反应种属: Human, Mouse
-
分类: 科研抗体货号: P07376别名: IL-15应用: IHC反应种属: Human

鄂公网安备42018502007531号
鄂公网安备42018502007531号

